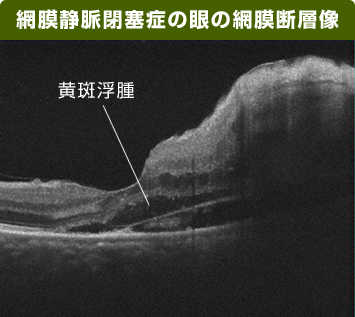

網膜静脈閉塞症の治療の効果を確認したり、再発していないかを確認するためには、定期的に検査を受けることが大切です。主に、下記のような検査を行って、確認・判断します。
1.視力検査
視力表を用いて測定します。眼鏡などを使わずに測定し(裸眼視力といいます)、基準となる視力が得られない場合は、検査用の眼鏡を用いて、最大の視力(矯正視力といいます)が出るまでレンズを替えて調べます。

どこまで小さい文字が見えるかによって視力を判定します。
2.眼底検査
細隙灯顕微鏡を用いるなどして、眼底にある網膜の状態を調べます。細隙灯顕微鏡から、眼底に細くて強い光を当て、病気の所見を拡大して調べます。眼底出血の状態や黄斑浮腫、硝子体出血の有無などが観察できます。

写真提供:日本大学 名誉教授 湯澤 美都子先生

写真提供:滋賀医科大学 大路 正人先生
3.網膜断層検査(光干渉断層計)
光干渉断層計を用いて、眼底組織の断面の状態を詳しく調べます。光干渉断層計は、網膜の断面を画き出します。この検査で、網膜静脈閉塞症による黄斑の浮腫の状態が確認できます。

写真提供:日本大学 名誉教授 湯澤 美都子先生
写真提供:滋賀医科大学 大路 正人先生
4.フルオレセイン蛍光眼底造影
蛍光色素を含んだ造影剤を腕の静脈から注射し、眼底カメラで眼底の血管の異常を検査します。静脈から漏れた水分や血液の存在や、新生血管の有無を確認します。また、造影剤を注射してから動脈や静脈の画像があらわれるまでの時間を測ることで、静脈の閉塞の度合いを判断することもできます。

写真提供:滋賀医科大学 大路 正人先生